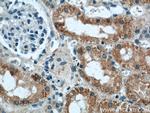
IFT88 Antibody in Immunohistochemistry (Paraffin) (IHC (P))

Search
Proteintech
IFT88 Monoclonal Antibody (4A4G5)
{{$productOrderCtrl.translations['antibody.pdp.commerceCard.promotion.promotions']}}
{{$productOrderCtrl.translations['antibody.pdp.commerceCard.promotion.viewpromo']}}
{{$productOrderCtrl.translations['antibody.pdp.commerceCard.promotion.promocode']}}: {{promo.promoCode}} {{promo.promoTitle}} {{promo.promoDescription}}. {{$productOrderCtrl.translations['antibody.pdp.commerceCard.promotion.learnmore']}}
产品信息
60227-1-IG
种属反应
已发表种属
宿主/亚型
分类
类型
克隆号
抗原
偶联物
形式
浓度
规格
纯化类型
保存液
内含物
保存条件
运输条件
产品详细信息
This antibody was raised against the C-terminal region of human IFT88 and can detect the endogenous level of IFT88.
Immunogen sequence: NIGLTYEKL NRLDEALDCF LKLHAILRNS AEVLYQIANI YELMENPSQA IEWLMQVVSV IPTDPQVLSK LGELYDRGGD KSQAFQYYYE SYRYFPCNIE VIEWLGAYYI DTQFWEKAIQ YFERASLIQP TQVKWQLMVA SCFRRSGNYQ KALDTYKDTH RKFPENVECL RFLVRLCTDL GLKDAQEYAR KLKRLEKMKE IREQRIKSGR DGSGGSRGKR EGSASGDSGQ NYSASSKGER LSARLRALPG TNEPYESSSN KEIDASYVDP LGPQIERPKT AAKKRIDEDD FADEELGDDL LPE (532-833 aa encoded by BC030776)
靶标信息
This gene encodes a member of the tetratrico peptide repeat family. Mutations of a similar gene in mouse can cause polycystic kidney disease. Two transcript variants encoding distinct isoforms have been identified for this gene.
仅用于科研。不用于诊断过程。未经明确授权不得转售。
生物信息学
蛋白别名: HGNC:20606; intraflagellar transport 88 homolog; Intraflagellar transport protein 88 homolog; MGC26259; mutations in the mouse Tg737 gene cause polycystic kidney disease; polaris homolog; probe hTg737 (polycystic kidney disease, autosomal recessive); Recessive polycystic kidney disease protein Tg737; Recessive polycystic kidney disease protein Tg737 homolog; RP11-172H24.2; testicular tissue protein Li 93; tetratricopeptide repeat domain 10; Tetratricopeptide repeat protein 10; Tg737 protein; TgN(Imorpk)737Rpw; TPR repeat protein 10; transgene insert site 737, insertional mutation, polycystic kidney disease; unnamed protein product
基因别名: AW552028; D13S1056E; DAF19; flexo; fxo; hTg737; IFT88; orpk; polaris; TG737; Tg737Rpw; TgN737Rpw; TTC10
UniProt ID: (Human) Q13099, (Mouse) Q61371
Entrez Gene ID: (Human) 8100, (Mouse) 21821, (Rat) 305918